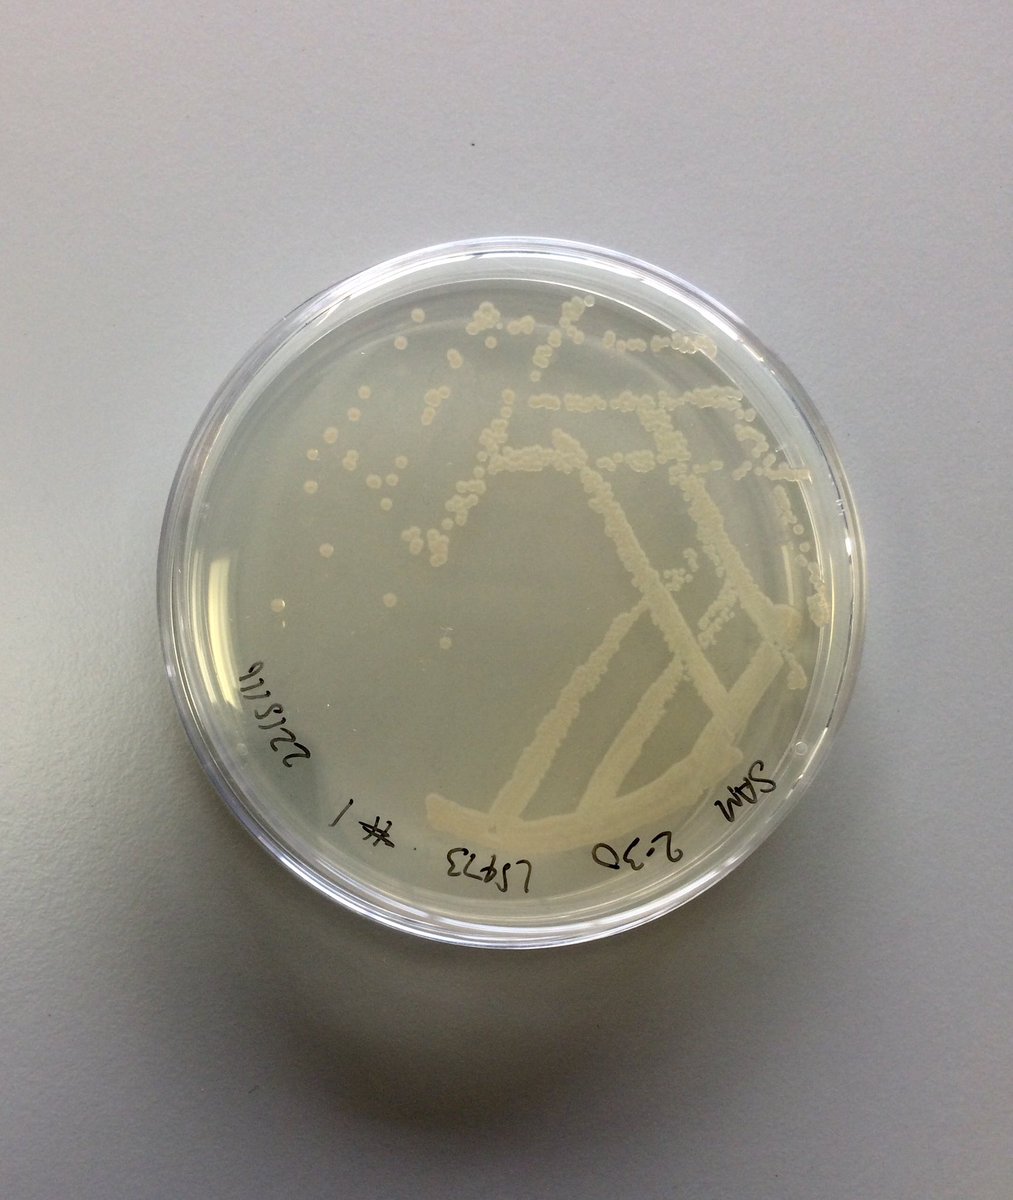
In 1988 one such micro-organism - called Shewanella oneidensis - was isolated from the sediments of Lake Oneida, New York State. It’s able to survive in environments with little or no oxygen!In a lab, it can be grown on an agar plate (a nutrient-rich jelly) 2/8

Quick thread on one of my favourite things: electric bacteria 

Micro-organisms are amazing because they can live in extreme environments. For example, around hydrothermal vents and volcanic springs, under the ice in Antarctica, and at the bottom of lakes
1/8


Micro-organisms are amazing because they can live in extreme environments. For example, around hydrothermal vents and volcanic springs, under the ice in Antarctica, and at the bottom of lakes
1/8
In 1988 one such micro-organism - called Shewanella oneidensis - was isolated from the sediments of Lake Oneida, New York State. It’s able to survive in environments with little or no oxygen!
In a lab, it can be grown on an agar plate (a nutrient-rich jelly)
2/8
In a lab, it can be grown on an agar plate (a nutrient-rich jelly)

2/8
Shewanella can also be grown in a nutrient-rich liquid called LB (lysogeny broth) within conical flasks or sealed glass tubes
With the latter, the gases in the tube can be analysed to see whether oxygen is present and other products have been made by the bacteria
3/8
With the latter, the gases in the tube can be analysed to see whether oxygen is present and other products have been made by the bacteria
3/8
To survive without oxygen, Shewanella can break down food and then transfer electrons to solid rocks / minerals in the environment using proteins called cytochromes
Production of cytochromes gives Shewanella a bright red colour because they contain iron
4/8 [ @Teatimesci]
@Teatimesci]
Production of cytochromes gives Shewanella a bright red colour because they contain iron
4/8 [
 @Teatimesci]
@Teatimesci]
An example of a Shewanella cytochrome is MtrC, represented in the cartoon by a blue line (for the amino acid chain) and black dots (for iron atoms)
Electrons “hop” between the iron atoms almost like a flow of electricity - hence the name electric bacteria
5/8 [PDB ID = 4LM8]
Electrons “hop” between the iron atoms almost like a flow of electricity - hence the name electric bacteria

5/8 [PDB ID = 4LM8]
Electricity made by Shewanella can be captured using devices called microbial fuel cells 
They contain electrodes and wires that replace the solid rocks / minerals in the environment and collect the electrons released after bacteria break down their food
6/8

They contain electrodes and wires that replace the solid rocks / minerals in the environment and collect the electrons released after bacteria break down their food
6/8
This process can also be reversed, so electrons can be “pushed” into bacteria and used to make valuable chemicals (such as hydrogen) from simple building blocks 
The electrons could come from an electrode or from compounds that absorb light (called photosensitisers)
7/8

The electrons could come from an electrode or from compounds that absorb light (called photosensitisers)
7/8

 Read on Twitter
Read on Twitter

![To survive without oxygen, Shewanella can break down food and then transfer electrons to solid rocks / minerals in the environment using proteins called cytochromes Production of cytochromes gives Shewanella a bright red colour because they contain iron4/8 [ @Teatimesci] To survive without oxygen, Shewanella can break down food and then transfer electrons to solid rocks / minerals in the environment using proteins called cytochromes Production of cytochromes gives Shewanella a bright red colour because they contain iron4/8 [ @Teatimesci]](https://pbs.twimg.com/media/EfuA82GWsAEpG4F.jpg)
![An example of a Shewanella cytochrome is MtrC, represented in the cartoon by a blue line (for the amino acid chain) and black dots (for iron atoms)Electrons “hop” between the iron atoms almost like a flow of electricity - hence the name electric bacteria 5/8 [PDB ID = 4LM8] An example of a Shewanella cytochrome is MtrC, represented in the cartoon by a blue line (for the amino acid chain) and black dots (for iron atoms)Electrons “hop” between the iron atoms almost like a flow of electricity - hence the name electric bacteria 5/8 [PDB ID = 4LM8]](https://pbs.twimg.com/media/EfuA9UsXgAETNF6.jpg)








